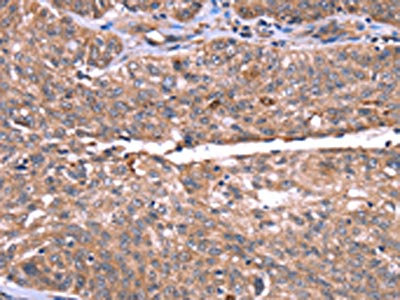

HRG Antibody
-
中文名稱:HRG兔多克隆抗體
-
貨號:CSB-PA181107
-
規格:¥1100
-
圖片:
-
The image on the left is immunohistochemistry of paraffin-embedded Human breast cancer tissue using CSB-PA181107(HRG Antibody) at dilution 1/50, on the right is treated with synthetic peptide. (Original magnification: ×200)
-
The image on the left is immunohistochemistry of paraffin-embedded Human ovarian cancer tissue using CSB-PA181107(HRG Antibody) at dilution 1/50, on the right is treated with synthetic peptide. (Original magnification: ×200)
-
-
其他:
產品詳情
-
Uniprot No.:
-
基因名:HRG
-
別名:HRG antibody; Histidine-rich glycoprotein antibody; Histidine-proline-rich glycoprotein antibody; HPRG antibody
-
宿主:Rabbit
-
反應種屬:Human
-
免疫原:Synthetic peptide of Human HRG
-
免疫原種屬:Homo sapiens (Human)
-
標記方式:Non-conjugated
-
抗體亞型:IgG
-
純化方式:Antigen affinity purification
-
濃度:It differs from different batches. Please contact us to confirm it.
-
保存緩沖液:-20°C, pH7.4 PBS, 0.05% NaN3, 40% Glycerol
-
產品提供形式:Liquid
-
應用范圍:ELISA,IHC
-
推薦稀釋比:
Application Recommended Dilution ELISA 1:2000-1:5000 IHC 1:50-1:200 -
Protocols:
-
儲存條件:Upon receipt, store at -20°C or -80°C. Avoid repeated freeze.
-
貨期:Basically, we can dispatch the products out in 1-3 working days after receiving your orders. Delivery time maybe differs from different purchasing way or location, please kindly consult your local distributors for specific delivery time.
-
用途:For Research Use Only. Not for use in diagnostic or therapeutic procedures.
相關產品
靶點詳情
-
功能:Plasma glycoprotein that binds a number of ligands such as heme, heparin, heparan sulfate, thrombospondin, plasminogen, and divalent metal ions. Binds heparin and heparin/glycosaminoglycans in a zinc-dependent manner. Binds heparan sulfate on the surface of liver, lung, kidney and heart endothelial cells. Binds to N-sulfated polysaccharide chains on the surface of liver endothelial cells. Inhibits rosette formation. Acts as an adapter protein and is implicated in regulating many processes such as immune complex and pathogen clearance, cell chemotaxis, cell adhesion, angiogenesis, coagulation and fibrinolysis. Mediates clearance of necrotic cells through enhancing the phagocytosis of necrotic cells in a heparan sulfate-dependent pathway. This process can be regulated by the presence of certain HRG ligands such as heparin and zinc ions. Binds to IgG subclasses of immunoglobins containing kappa and lambda light chains with different affinities regulating their clearance and inhibiting the formation of insoluble immune complexes. Tethers plasminogen to the cell surface. Binds T-cells and alters the cell morphology. Modulates angiogenesis by blocking the CD6-mediated antiangiongenic effect of thrombospondins, THBS1 and THBS2. Acts as a regulator of the vascular endothelial growth factor (VEGF) signaling pathway; inhibits endothelial cell motility by reducing VEGF-induced complex formation between PXN/paxillin and ILK/integrin-linked protein kinase and by promoting inhibition of VEGF-induced tyrosine phosphorylation of focal adhesion kinases and alpha-actinins in endothelial cells. Also plays a role in the regulation of tumor angiogenesis and tumor immune surveillance. Normalizes tumor vessels and promotes antitumor immunity by polarizing tumor-associated macrophages, leading to decreased tumor growth and metastasis.
-
基因功能參考文獻:
- The HRG C633T genotype seems to be associated with gestational hypertensive disorders PMID: 29540166
- A novel heterozygous single base pair substitution in exon 2 of HRG gene identified in a familial early-onset deep venous thrombosis case. PMID: 29108964
- presence of HRG mRNA did not depend on the cancer type, on the preoperative treatment or its absence, as well as on the tumor progression stage and the presence of metastases PMID: 29536307
- C633T SNP had no significant effect on sperm DNA integrity PMID: 28356499
- once infertility is established the HRG C633T SNP seems to be important for male infertility and pregnancy rate following IVF PMID: 27210772
- These data highlight the complex divalent metal-dependent regulatory mechanisms that govern HRG function. PMID: 27930811
- HRG attenuates DNA- and RNA-mediated FXII activation, and FXI activation by FXIIa or by thrombin, suggesting that HRG down regulates the capacity of DNA and RNA to activate the intrinsic coagulation pathway. PMID: 26354857
- HRG binds to alpha2 integrin through low-affinity interactions in a heparin sulfate-independent manner, thereby blocking endothelial cells adhesion to collagen I. PMID: 26051322
- HRG could inhibit hepatocellular carcinoma cell proliferation via the FGF-Erk1/2 signaling pathway by reducing Erk1/2 phosphorylation. PMID: 26336134
- Plasma free fatty acid levels influence Zn(2+) -dependent histidine-rich glycoprotein-heparin interactions via an allosteric switch on serum albumin. PMID: 25353308
- mononuclear phagocytes have specific binding sites for HRG and that these cells are essential for uptake of HRG from blood and distribution of HRG in tissues. Thus, inflammatory cells mediate the effect of HRG on tumor growth and metastatic spread. PMID: 25243896
- Results show that HRG is a novel transcriptional target gene of FXR in human hepatoma cells, human upcyteVR primary hepatocytes and 3D human liver microtissues in vitro and in mouse liver in vivo. PMID: 25363753
- genetic association study in Swedish population: Data suggest SNP in HRG (rs2228243, A1042G) is associated with recurrent miscarriage in population studied; women heterozygous for HRG A1042G SNP are protected from recurrent miscarriage. [PILOT STUDY] PMID: 25064236
- The protein encoded by this gene has a peptide that displays antimicrobial activity against C. albicans, E. coli, S. aureus, P. aeruginosa, and E. faecalis. PMID: 18797515
- histidine-rich glycoprotein tissue RNA and serum protein might have a role in breast cancer PMID: 24567057
- HRG does not exhibit the broad interactive properties that have been reported previously, suggesting that copurification of HRG-binding partners or other impurities are responsible for some of the reported functional properties. PMID: 23576524
- Association between the histidine-rich glycoprotein (HRG) C633T single nucleotide polymorphism (SNP) and recurrent miscarriage was investigated. An association between homozygous carriers and recurrent miscarriage was detected. PMID: 23672470
- The combination of lowered HRG and uterine artery Doppler may predict preterm preeclampsia in early pregnancy. PMID: 22895448
- the genetic polymorphism (rs9898 C/T) in the HRG gene of a woman affects her chances of becoming pregnant after IVF PMID: 21665544
- the HRG-fibrin interaction may provide a novel link between coagulation, innate immunity, and inflammation PMID: 21757718
- by binding to factor XIIa, HRG modulates the intrinsic pathway of coagulation, particularly in the vicinity of a thrombus where platelet release of HRG and Zn(2)(+) will promote this interaction PMID: 21304106
- Host-produced HRG inhibits tumor growth and metastasis by skewing tumor-associated macrophages (TAM) polarization away from the M2- to a tumor-inhibiting M1-like phenotype. Skewing of TAM polarization by HRG relies substantially on downregulation of PlGF. PMID: 21215706
- HRG can aid the phagocytosis of necrotic cells via a heparan sulfate-dependent pathway, and this process can be regulated by the presence of certain HRG ligands, such as heparin. PMID: 20573803
- Single Nucleotide Polymorphisms in HRG is associated with activated partial thromboplastin time. PMID: 20303064
- HRG has the unique property of complexing with IgG and facilitating a proinflammatory innate immune response to promote the clearance of necrotic cells PMID: 20071662
- By acting as a bridge between DNA on apoptotic cells and Fc gamma RI on monocyte-derived macrophages, HRG is a key physiological mediator of apoptotic cell clearance by macrophages. PMID: 12391183
- Data indicate that histidine-rich glycoprotein, in combination with the zinc ion, modulates the smooth muscle cell growth response in pathophysiological states. PMID: 12764609
- Histidine-rich glycoprotein binds to cell-surface heparan sulfate via its N-terminal domain following Zn2+ chelation PMID: 15138272
- HRG acts as a soluble adaptor molecule that binds to cells at sites of tissue injury, tumor growth, and angiogenesis PMID: 15220341
- HPRG binds to endothelial cell surface tropomyosin which at least partially mediates the antiangiogenic effects of HPRG PMID: 15269838
- HRG has the unique property of selectively recognizing necrotic cells and may play an important physiological role in vivo by facilitating the uptake and clearance of necrotic, but not apoptotic, cells by phagocytes PMID: 16107330
- the anti-angiogenic His/Pro-rich fragment of histidine-rich glycoprotein binds to endothelial cell heparan sulfate in a Zn2+-dependent manner PMID: 16436387
- the histidine-rich and heparin-binding domain of HRGP mediates the antibacterial activity of the protein PMID: 17229145
- identified the alpha-subunit of ATP synthase as one of the HRG-binding proteins on the surface of T-cells by HRG-derived glycopeptide affinity chromatography and by a peptide mass finger printing method PMID: 19285951
- HRG may assist in the maintenance of normal immune function by mediating the clearance of necrotic material, inhibiting the formation of insoluble immune complexes and enhancing their ability to activate complement, resulting in faster clearance. PMID: 19674792
- Proteolytic cleavage of HRG by plasmin may provide a feedback mechanism to regulate the effects of HRG on the plasminogen/plasmin system and other functions of HRG. PMID: 19712047
顯示更多
收起更多
-
相關疾病:Thrombophilia due to histidine-rich glycoprotein deficiency (THPH11)
-
亞細胞定位:Secreted.
-
組織特異性:Expressed in macrophages and in malignant cells. Expressed by the liver and secreted in plasma (at protein level).
-
數據庫鏈接:
Most popular with customers
-
-
YWHAB Recombinant Monoclonal Antibody
Applications: ELISA, WB, IHC, IF, FC
Species Reactivity: Human, Mouse, Rat
-
Phospho-YAP1 (S127) Recombinant Monoclonal Antibody
Applications: ELISA, WB, IHC
Species Reactivity: Human
-
-
-
-
-